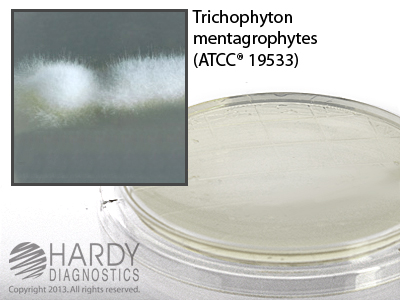
Potato Dextrose Agar (PDA) with Sodium Thiosulfate

Details
- Manufacturer: Hardy
- Mfr. Cat. # P67
- Brand Name: Hardy
Microbiology » Culture Media Plates
Potato Dextrose Agar (PDA) with Sodium Thiosulfate
Medix Item Code: HPD-0P67
$56.66 per Pack
List Price: $63.39
You Save: $6.73 (11%)
Size: 10/pk
This product has been discontinued
Similar products may be available below.
Special shipping requirements
- Refrigerated - This item is refrigerated and must ship by air with ice.
Features
- For the recovery fungi on surfaces disinfected with chlorine.